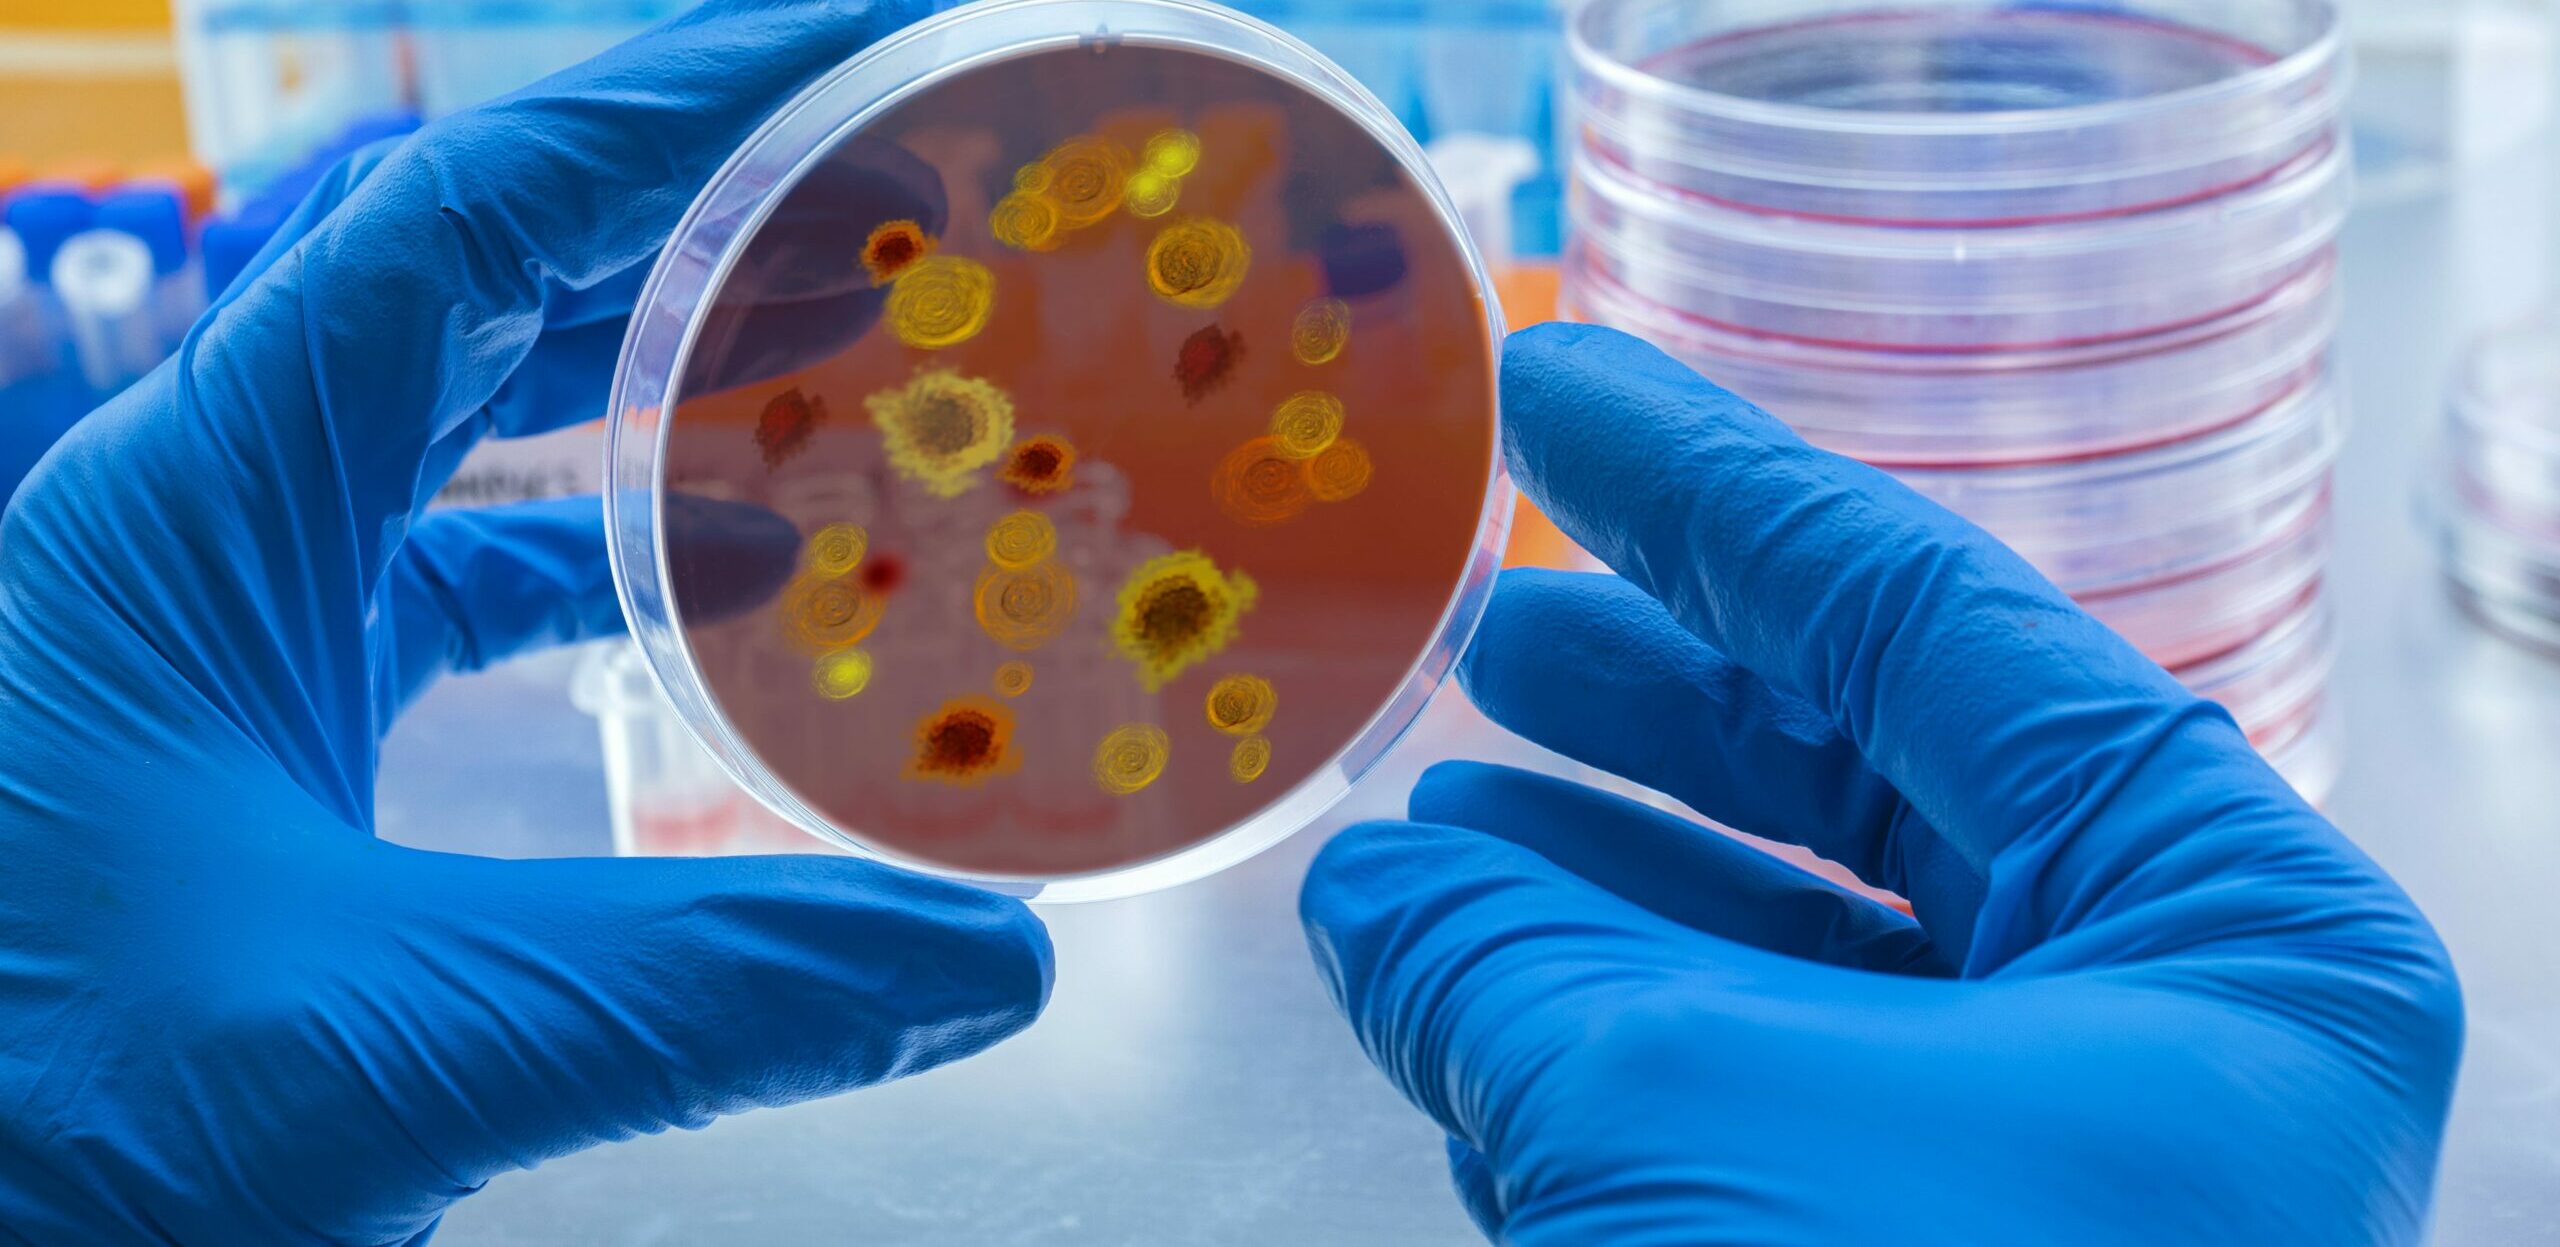
Dengue hemorrágica: O que é, sintomas, tratamentos e causas

:format(webpp))
A dengue é uma doença causada por um vírus transmitido pelo mosquito Aedes Aegypti. Existem duas formas clínicas principais: a dengue clássica e a dengue hemorrágica . Este tipo é considerado mais grave, uma vez que pode evoluir rapidamente e levar à morte caso não seja tratado rapidamente.
“Assim como nos casos de dengue clássica, a dengue hemorrágica se dá pela picada do mosquito Aedes aegypti infectado pelo vírus da dengue. Dessa forma, a pessoa picada por um mosquito que carrega o vírus pode levar de 3 a 15 dias para apresentar sintomas.”
De acordo com o imunologista, Tales Shibata, gerente médico na Sami, grande parte dos casos de dengue hemorrágica se dá em pessoas que já tiveram dengue anteriormente. Porém, também pode acometer quem nunca teve dengue antes; crianças jovens e bebês também tem mais evolução para a forma grave.
Os sintomas iniciais de dengue hemorrágica são os mesmos que ocorrem na forma clássica de dengue: o início se dá com uma fase de febre, dores do corpo e articulações, dor de cabeça , dor nos olhos e pequenas manchas vermelhas pelo corpo. A partir do terceiro dia, os sintomas tendem a ficar mais graves, se a pessoa for evoluir para a forma hemorrágica. Alguns sinais de alerta para a possibilidade de evolução à dengue hemorrágica são, por exemplo:
Acima de tudo, é fundamental que o paciente observe os sinais de alerta acima e procure um hospital o quanto antes. Para confirmação do diagnóstico, o médico vai realizar o exame físico e a prova do laço, que consiste em pressionar o braço com uma fita ou com o aparelho que afere a pressão e desenhar um quadrado de 2,5 x 2,5 cm na pele. E após 5 minutos observar se há mais de 20 pintinhas vermelhas dentro do quadrado.
Além disso, os profissionais também solicitam alguns exames clínicos adicionais, como hemograma, coagulograma, e , a depender do tempo de doença, os anticorpos contra o vírus da dengue ou a pesquisa das proteínas do vírus. Assim, essas pesquisas são importantes para fazer os diagnósticos diferenciais com zika ou chikungunya, viroses também transmitidas pelo mesmo mosquito e com sintomas semelhantes.
O tratamento da dengue hemorrágica é feito com hidratação através de soro direto na veia. Por se tratar de uma doença grave que pode causar alterações respiratórias, hepáticas e cardíacas, o paciente deve ficar internado no hospital, onde a equipe médica pode monitorá-lo.
“O tratamento deve começar imediatamente após o diagnóstico positivo. Vale lembrar que em casos de suspeita de dengue, medicamentos com ácido acetilsalicílico, anticoagulantes ou anti-inflamatórios devem ser evitados”, esclarece o médico.
Leia também: Mortes por dengue em 2022 ultrapassam o dobro do ano passado
Não há como prevenir que uma pessoa com dengue clássica desenvolva a forma grave . , Mas é possível prevenir o surgimento da dengue com algumas medidas simples:
“Se o tratamento não for iniciado rapidamente, há risco de morte, porque neste tipo de dengue pode haver o que chamamos de choque, que gera prostração, palidez das mucosas e da pele, sudorese, aceleração do pulso e queda acentuada da pressão arterial, além de dificuldade para respirar e comprometimento grave do coração, rins, fígado e cérebro”, completa o especialista.
Fonte: Tales Shibata, imunologista, gerente médico na Sami e especialista em alergia e imunologia pediátrica pela Escola Paulista de Medicina – UNIFESP.